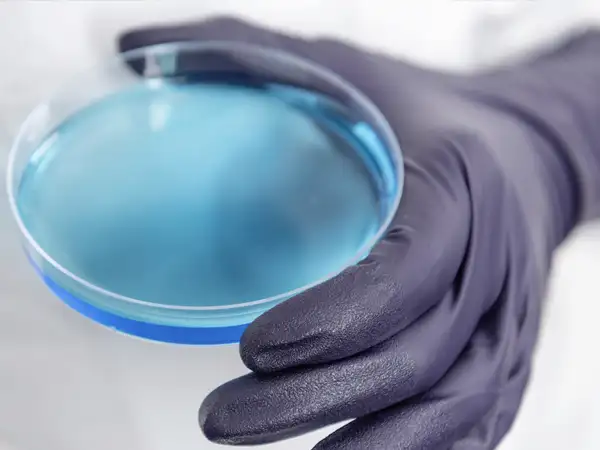

Révision de la norme Afnor NF S 90 351

Hygiacare Conseil par le biais de sa dirigeante est fortement impliquée dans la révision de la norme française Afnor NF S 90 351
validation par le Ministère de la transition écologique et cohésion du territoire

HygiaCare Conseil, a reçu sa validation par le Ministère de la transition écologique et cohésion du territoire pour animer des formations relatives à l’obtention du Certibiocide « Désinfectant » pour tout utilisateur professionnel et distributeur de certains types de produits biocides.
Aérosols et risques biologiques et REUT

HygiaCare Conseil démarre les phases expérimentales du projet R&D « aérosols et risques biologiques et REUT » en partenariat avec Toulouse Métropole et ASTEO
Qualité de l’air dans les zones à atmosphère contrôlée

HygiaCare Conseil par le biais de Virginie Griotto, est responsable de l’animation du groupe de travail n°1 de la norme Afnor NF S 90 351.
Retour d’expérience

Les experts au services des professionnels de santé – Interview de Virginie Griotto dans la revue BÂTIMENT.
Norme NF EN17141, maîtrise de la biocontamination
Norme NF EN17141, maîtrise de la biocontamination. Enjeux et analyse des risques et de la sécurisation.
HygiaCare Conseil renouvelle sa certification Qualiopi

Depuis 2021, notre bureau d’études est certifié Qualiopi. Télécharger notre catalogue de formation.